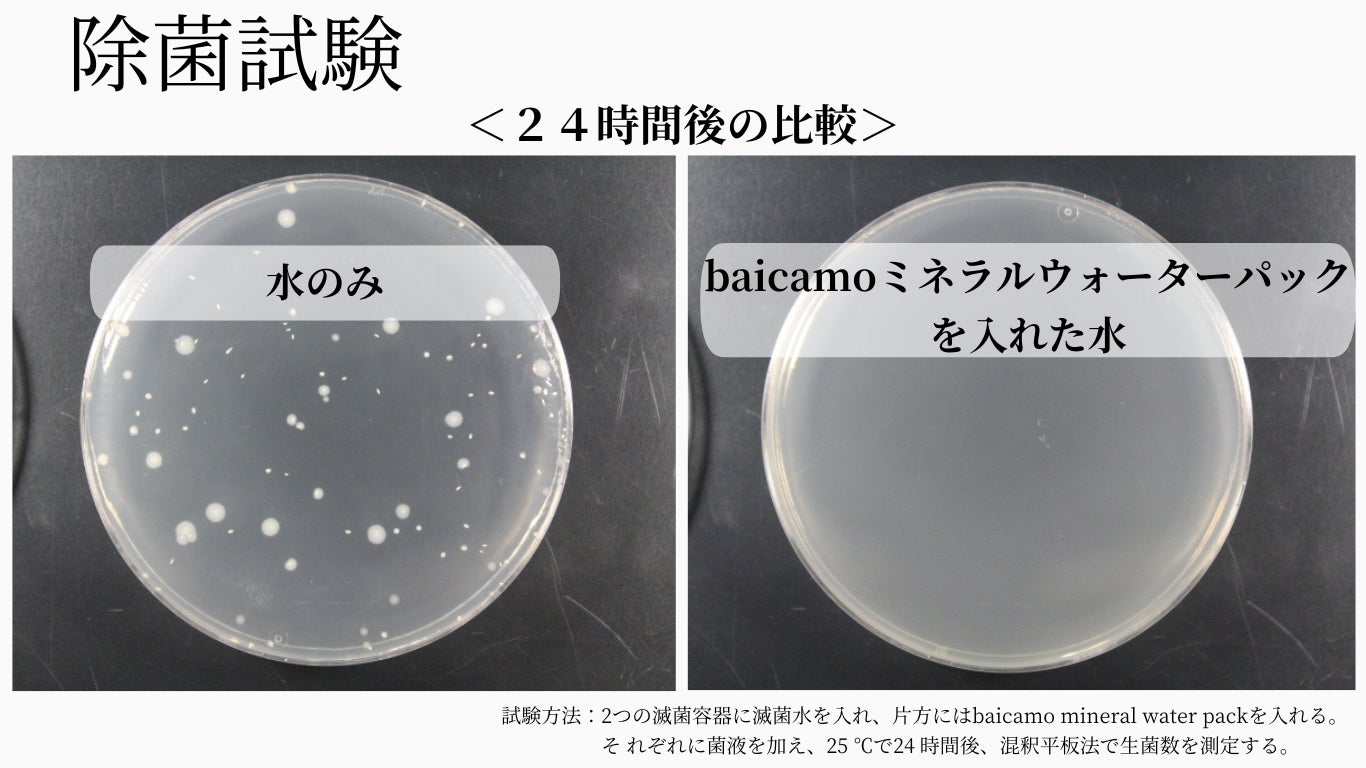

[新商品]水のプロが本気で開発!美味しい水を作るbaicamoミネラルウォーターパック
baicamoミネラルウォーターパックは、特許取得済みの飲用水基準をクリアしたセラミックスを配合。浄水、脱臭、除菌効果があり、美味しい水を作り、水の美味しさを保つ商品です。

こんな悩みはありませんか?
毎日必ず飲む水は美味しいほうがいいですよね。しかし、ペットボトルを毎回買うのは高い…マイボトルを持ち歩きたいけど、水道水は塩素臭が気になる。外出先で飲みかけの水の衛生面は気になる…麦茶やコーヒーだとボトルにニオイがついて、その後に水を入れるのはためらう。など、たくさんあるこれらの悩み…
それが、baicamoミネラルウォーターパックを入れるだけで解決できちゃうんです。同じ悩みを持つ、水を愛するすべての人へ。お試しいただければ嬉しいです。
【商品の特長】
-
美味しい水を作る。マイボトルに入れるだけ。いつでもどこでも美味しさを保つ
-
浄水、脱臭、除菌。素材にこだわり日本製。特許取得のセラミックスを配合
-
繰り返し使えて経済的!さらに使用後は脱臭剤として再利用でとってもエコ
それほしい!の声から生まれたbaicamoミネラルウォーターパック

baicamoミネラルウォーターパックはマイボトルに入れるだけ。使い始めに水道水で軽くすすいでマイボトルに入れるだけです。しかも繰り返し使用が可能です。使用環境や使用する水にもよりますが、約180回使用が可能です。水を美味しく、水の美味しさを保ちます。
水のプロが長年培った知識と技術を生かして開発

baicamoミネラルウォーターパックに使用している素材はすべて日本製にこだわり、いくつもの素材で試験を重ね、試行錯誤して完成した商品です。日本の厳しい飲用水基準をクリアした天然素材のセラミックスのみを数種類配合しています。それぞれの素材が機能し、ミネラル豊富な美味しい水に変わります。
浄水、脱臭、除菌の効果でマイボトルのお水を美味しく保つ
浄水、脱臭、除菌効果があるため、水を美味しく、さらに美味しさを保ちます。水道水の塩素や不純物を除去し、カルキ臭も取り除きます。マイボトルに付く独特なニオイを除去、雑菌を除去する効果もあり、baicamoミネラルウォーターパックが1つあると便利です。
使い捨てプラスチックゼロで美味しい水を楽しめる


baicamoミネラルウォーターパックがあれば、使い捨てプラスチックゼロで美味しい水を楽しめます。ペットボトルを買わずに済むため、マイボトルの利用を促進し、使い捨てプラスチックの削減に貢献します。使用後は冷蔵庫や靴の脱臭剤として利用可能なのもうれしいポイント。最後は植木鉢などに入れて再利用ができるため、環境に優しい商品です。持続可能な未来のために、baicamoミネラルウォーターパックを活用してみませんか?
【商品概要】

商品名:baicamoミネラルウォーターパック
内容量:1箱に1個入り
原材料:活性炭、ビタミンCセラミックス、麦飯石セラミックス、サンゴセラミックス、中性除菌セラミックス、不織布
生産国:日本
マクアケにて先行販売中!
このプレスリリースには、メディア関係者向けの情報があります
メディアユーザー登録を行うと、企業担当者の連絡先や、イベント・記者会見の情報など様々な特記情報を閲覧できます。※内容はプレスリリースにより異なります。
すべての画像